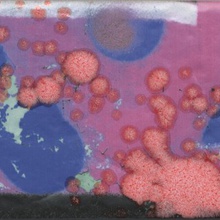
Kerama Marazzi Граффити OS\A57\9x\19060 Панно 20x89,1 см, Россия, ничего - фото 1 - фото 4

- Шоурумы
- Услуги
- Клиентам
- 3D дизайн
- Контакты
- Дизайнерам
Интерьеров пока нет
Добавьте интерьеры через кнопку закладки.
Список сравнения пуст
Добавьте товары к сравнению через кнопку с весами.
+7 (495) 966-18-01
Пн-Пт 8:00—20:00
Сб-Вс 8:00—20:00


Страна
 Россия
Россия
Фабрика Kerama Marazzi
Коллекция Граффити
Размер: 9.9x20 см
Материал: Керамика
Имитация: другое
Фабричный цвет: Белый
Цена от 1 591 руб.
Доставка по Москве 1-5 дней,
по России 5-10 дней
Оплата наличными, картой,
по счету с НДС
Дизайн-проект в подарок
Скидки на большие заказы
Сотрудничаем с дизайнерами

Kerama Marazzi Граффити 19061 Черный настенная плитка 9,9x20
Артикул: 19061
Страна-производитель:  Россия
Россия
Фабрика: Kerama Marazzi
Коллекция: Граффити
Размер: 9.9x20 см
Материал: Керамика
Имитация: под бетон / цемент
Код товара: 762354 Код товара: контур стойкой территории
Цена 1 744 руб./м²
Наличие: 1.66 м²

Kerama Marazzi Граффити 19066 Серый настенная плитка 9,9x20
Артикул: 19066
Страна-производитель:  Россия
Россия
Фабрика: Kerama Marazzi
Коллекция: Граффити
Размер: 9.9x20 см
Материал: Керамика
Имитация: под бетон / цемент
Код товара: 762349 Код товара: контур стойкой судьбы
Цена 1 591 руб./м²
Наличие: 6.31 м²

Kerama Marazzi Граффити 19060 Белый настенная плитка 9,9x20
Артикул: 19060
Страна-производитель:  Россия
Россия
Фабрика: Kerama Marazzi
Коллекция: Граффити
Размер: 9.9x20 см
Материал: Керамика
Имитация: под бетон / цемент
Код товара: 762352 Код товара: контур стойкой темноты
Цена 1 591 руб./м²
Наличие: 15.65 м²

Kerama Marazzi Граффити 19065 Серый Светлый настенная плитка 9,9x20
Артикул: 19065
Страна-производитель:  Россия
Россия
Фабрика: Kerama Marazzi
Коллекция: Граффити
Размер: 9.9x20 см
Материал: Керамика
Имитация: под бетон / цемент
Код товара: 762351 Код товара: контур стойкой тайны
Цена 1 591 руб./м²
Наличие: 19.14 м²

Kerama Marazzi Граффити 19067 Серый Темный настенная плитка 9,9x20
Артикул: 19067
Страна-производитель:  Россия
Россия
Фабрика: Kerama Marazzi
Коллекция: Граффити
Размер: 9.9x20 см
Материал: Керамика
Имитация: под бетон / цемент
Код товара: 762353 Код товара: контур стойкой тени
Цена 1 651 руб./м²
Наличие: 76.34 м²

Kerama Marazzi Граффити TG\B04\19066 Серый декор 9,9x20
Артикул: TG\B04\19066
Страна-производитель:  Россия
Россия
Фабрика: Kerama Marazzi
Коллекция: Граффити
Размер: 9.9x20 см
Материал: Керамика
Имитация: под металл
Код товара: 763078 Код товара: контур триумфальной раковины
Цена 268 руб./шт
Наличие: 69 шт

Kerama Marazzi Граффити TG\C04\19067 Серый Темный декор 9,9x20
Артикул: TG\C04\19067
Страна-производитель:  Россия
Россия
Фабрика: Kerama Marazzi
Коллекция: Граффити
Размер: 9.9x20 см
Материал: Керамика
Имитация: под металл
Код товара: 763079 Код товара: контур триумфальной реки
Цена 268 руб./шт
Наличие: 17 шт

Kerama Marazzi Граффити TG\A04\19065 Серый Светлый декор 9,9x20
Артикул: TG\A04\19065
Страна-производитель:  Россия
Россия
Фабрика: Kerama Marazzi
Коллекция: Граффити
Размер: 9.9x20 см
Материал: Керамика
Имитация: под металл
Код товара: 763077 Код товара: контур триумфальной радости
Цена 268 руб./шт
Наличие: 67 шт




Kerama Marazzi Граффити OS\A58\9x\19060 панно 20x89,1
Артикул: OS\A58\9x\19060
Страна-производитель:  Россия
Россия
Фабрика: Kerama Marazzi
Коллекция: Граффити
Размер: 20x89.1 см
Материал: Керамика
Имитация: ничего
Код товара: 763082 Код товара: контур триумфальной росы
Цена 2 361 руб./шт
Наличие: 5 шт

Kerama Marazzi Граффити OS\A57\9x\19060 панно 20x89,1
Артикул: OS\A57\9x\19060
Страна-производитель:  Россия
Россия
Фабрика: Kerama Marazzi
Коллекция: Граффити
Размер: 20x89.1 см
Материал: Керамика
Имитация: ничего
Код товара: 763081 Код товара: контур триумфальной астры
Цена 2 361 руб./шт
Наличие: 4 шт




Kerama Marazzi Граффити OP\A210\4x\19060 Из 4-х частей панно 20x39,6
Артикул: OP\A210\4x\19060
Страна-производитель:  Россия
Россия
Фабрика: Kerama Marazzi
Коллекция: Граффити
Размер: 20x39.6 см
Материал: Керамика
Имитация: ничего
Код товара: 763080 Код товара: контур триумфальной реликвии
Цена 945 руб./шт

Kerama Marazzi Граффити PRA003 Серый Светлый бордюр 2x20
Артикул: PRA003
Страна-производитель:  Россия
Россия
Фабрика: Kerama Marazzi
Коллекция: Граффити
Размер: 2x20 см
Материал: Керамика
Имитация: другое
Код товара: 762359 Код товара: контур стойкой туманности
Цена 163 руб./шт
Наличие: 55 шт

Kerama Marazzi Граффити PRA002 Черный бордюр 2x20
Артикул: PRA002
Страна-производитель:  Россия
Россия
Фабрика: Kerama Marazzi
Коллекция: Граффити
Размер: 2x20 см
Материал: Керамика
Имитация: другое
Код товара: 762356 Код товара: контур стойкой тоски
Цена 163 руб./шт

Kerama Marazzi Граффити PRA004 Серый бордюр 2x20
Артикул: PRA004
Страна-производитель:  Россия
Россия
Фабрика: Kerama Marazzi
Коллекция: Граффити
Размер: 2x20 см
Материал: Керамика
Имитация: другое
Код товара: 762357 Код товара: контур стойкой травы
Цена 163 руб./шт
Наличие: 6 шт

Kerama Marazzi Граффити PRA001 Белый бордюр 2x20
Артикул: PRA001
Страна-производитель:  Россия
Россия
Фабрика: Kerama Marazzi
Коллекция: Граффити
Размер: 2x20 см
Материал: Керамика
Имитация: другое
Код товара: 762355 Код товара: контур стойкой ткани
Цена 163 руб./шт
Наличие: 9 шт

Kerama Marazzi Граффити PRA005 Серый Темный бордюр 2x20
Артикул: PRA005
Страна-производитель:  Россия
Россия
Фабрика: Kerama Marazzi
Коллекция: Граффити
Размер: 2x20 см
Материал: Керамика
Имитация: другое
Код товара: 762358 Код товара: контур стойкой тропы
Цена 163 руб./шт
Наличие: 19 шт

Kerama Marazzi Граффити POD005 Бисер Желтый бордюр 0,6x20
Артикул: POD005
Страна-производитель:  Россия
Россия
Фабрика: Kerama Marazzi
Коллекция: Граффити
Размер: 0.6x20 см
Материал: Керамика
Фабричный цвет: Желтый
Имитация: другое
Код товара: 859721 Код товара: лепесток ароматной слезы
Цена 169 руб./шт
Наличие: 40 шт

Kerama Marazzi Граффити 11 Платина карандаш 1,5x20
Артикул: 11
Страна-производитель:  Россия
Россия
Фабрика: Kerama Marazzi
Коллекция: Граффити
Размер: 1.5x20 см
Материал: Керамика
Имитация: под металл
Код товара: 859760 Код товара: лепесток бархатной вибрации
Цена 291 руб./шт
Наличие: 64 шт

Kerama Marazzi Граффити 151 Белый матовый карандаш 1,5x20
Артикул: 151
Страна-производитель:  Россия
Россия
Фабрика: Kerama Marazzi
Коллекция: Граффити
Размер: 1.5x20 см
Материал: Керамика
Фабричный цвет: Белый
Имитация: ничего
Код товара: 929505 Код товара: маятник мягкой бури
Цена 129 руб./шт
Наличие: 20 шт

Kerama Marazzi Граффити POF009 Бисер чёрный карандаш 1,4x20
Артикул: POF009
Страна-производитель:  Россия
Россия
Фабрика: Kerama Marazzi
Коллекция: Граффити
Размер: 1.4x20 см
Материал: Керамика
Фабричный цвет: Чёрный
Имитация: другое
Код товара: 860001 Код товара: лепесток ближней арфы
Цена 319 руб./шт
Наличие: 74 шт

Kerama Marazzi Граффити POD013 Бисер Фиолетовый карандаш 0,6x20
Артикул: POD013
Страна-производитель:  Россия
Россия
Фабрика: Kerama Marazzi
Коллекция: Граффити
Размер: 0.6x20 см
Материал: Керамика
Фабричный цвет: Фиолетовый
Имитация: другое
Код товара: 860373 Код товара: лепесток бурной юности
Цена 184 руб./шт
Наличие: 61 шт

Kerama Marazzi Граффити POD007 Бисер Розовый карандаш 0,6x20
Артикул: POD007
Страна-производитель:  Россия
Россия
Фабрика: Kerama Marazzi
Коллекция: Граффити
Размер: 0.6x20 см
Материал: Керамика
Фабричный цвет: Розовый
Имитация: другое
Код товара: 859805 Код товара: лепесток бархатной мудрости
Цена 184 руб./шт
Наличие: 91 шт
Коллекция керамической плитки Граффити Kerama Marazzi.


Купить плитку Карелли Kerama Marazzi
Страна-производитель:  Россия
Россия
Фабрика: Kerama Marazzi
Размер: 30x60, 60x60 см
Материал: Керамика
Имитация: под мрамор
Фабричный цвет: Микс
Рейтинг:
Код коллекции: 762375
Цена от 2 025 руб.



Плитка Ламбро Керама Марацци
Страна-производитель:  Россия
Россия
Фабрика: Kerama Marazzi
Размер: 20x120, 40x120 см
Материал: Керамика
Имитация: под дерево
Рейтинг:
Код коллекции: 762402
Цена от 2 231 руб.



Плитка Ломбардиа Kerama Marazzi 25x40 см
Страна-производитель:  Россия
Россия
Фабрика: Kerama Marazzi
Размер: 25x40 см
Материал: Керамика
Имитация: ничего
Фабричный цвет: Платина
Рейтинг:
Код коллекции: 762412
Цена от 1 132 руб.


Цены на плитку Матрикс Kerama Marazzi
Страна-производитель:  Россия
Россия
Фабрика: Kerama Marazzi
Размер: 20x20, 20x30, 30x30, 29.8x39.8 см
Материал: Керамогранит
Имитация: под камень / травертин / сланец / гранит
Фабричный цвет: Бежевый
Рейтинг:
Код коллекции: 762424
Цена от 992 руб.


Керамическая плитка Монтанелли Kerama Marazzi
Страна-производитель:  Россия
Россия
Фабрика: Kerama Marazzi
Материал: Керамика
Фабричный цвет: Бежевый Светлый
Имитация: под обои / ткань
Рейтинг:
Код коллекции: 762430
Цена от 175 руб.


Купить плитку Kerama Marazzi Навильи
Страна-производитель:  Россия
Россия
Фабрика: Kerama Marazzi
Размер: 15x15 см
Материал: Керамика
Имитация: под дерево
Рейтинг:
Код коллекции: 762442
Цена от 1 485 руб.

Недорогая плитка Kerama Marazzi Понти
Страна-производитель:  Россия
Россия
Фабрика: Kerama Marazzi
Материал: Керамика
Фабричный цвет: Серый
Имитация: под мозаику
Рейтинг:
Код коллекции: 762448
Цена от 335 руб.

Заказать плитку Семпионе Kerama Marazzi
Страна-производитель:  Россия
Россия
Фабрика: Kerama Marazzi
Размер: 30x89.5 см
Материал: Керамика
Имитация: под дерево
Фабричный цвет: Бежевый
Рейтинг:
Код коллекции: 762452
Цена от 2 281 руб.




Плитка Спига Kerama Marazzi
Страна-производитель:  Россия
Россия
Фабрика: Kerama Marazzi
Размер: 15x40 см
Материал: Керамика
Фабричный цвет: Белый
Имитация: ничего
Рейтинг:
Код коллекции: 762457
Цена от 1 322 руб.



Плитка Керама Марацци Стеллине
Страна-производитель:  Россия
Россия
Фабрика: Kerama Marazzi
Размер: 20x50 см
Материал: Керамика
Имитация: под камень / травертин / сланец / гранит
Фабричный цвет: Золото
Рейтинг:
Код коллекции: 762461
Цена от 1 447 руб.

Керамическая плитка Laparet Calacatta Superb (Россия)
Страна-производитель:  Индия
Индия
Фабрика: Laparet
Размер: 60x60, 60x120 см
Материал: Керамогранит
Имитация: под мрамор
Фабричный цвет: Серебро
Рейтинг:
Код коллекции: 743606
Цена от 1 190 руб.




Керамическая плитка Катания
Страна-производитель:  Испания
Испания
Фабрика: Mainzu
Размер: 15x30 см
Фабричный цвет: Blu
Имитация: под камень / травертин / сланец / гранит
Материал: Керамика
Рейтинг:
Код коллекции: 102787
Цена от 1 900 руб.



Decovita Chamber Newage цена на плитку
Страна-производитель:  Турция
Турция
Фабрика: Decovita
Размер: 60x120 см
Материал: Керамогранит
Имитация: под камень / травертин / сланец / гранит
Рейтинг:
Код коллекции: 527392
Цена от 2 001 руб.

L`antic colonial Essential фото керамической плитки в интерьре
Страна-производитель:  Испания
Испания
Фабрика: L`antic colonial (Porcelanosa Grupo)
Материал: Керамика
Фабричный цвет: Silver
Имитация: под мозаику
Рейтинг:
Код коллекции: 370590
Цена от 4 752 руб.

ФС Риалто купить керамическую плитку в Москве
Страна-производитель:  Испания
Испания
Фабрика: Peronda
Размер: 45.2x45.2 см
Материал: Керамогранит
Имитация: под камень / травертин / сланец / гранит
Рейтинг:
Код коллекции: 566108
Цена от 2 000 руб.


Напольная плитка Майнзу Риалто
Страна-производитель:  Испания
Испания
Фабрика: Mainzu
Размер: 15x15 см
Рейтинг:
Код коллекции: 308206
Цена от 1 463 руб.



Sonora купить плитку
Страна-производитель:  Испания
Испания
Фабрика: Cifre
Размер: 7.5x15 см
Материал: Керамика
Имитация: под камень / травертин / сланец / гранит
Рейтинг:
Код коллекции: 557550
Цена от 2 600 руб.




Купить плитку Марацци Треверкдир
Страна-производитель:  Италия
Италия
Фабрика: Marazzi
Размер: 25x150 см
Материал: Керамогранит
Имитация: под дерево
Рейтинг:
Код коллекции: 463283
Цена от 9 104 руб.

Плитка Трибека Испания
Страна-производитель:  Испания
Испания
Фабрика: GayaFores
Размер: 20.2x66.2, 15x90, 20x120, 45x90 см
Материал: Керамогранит
Имитация: под дерево
Рейтинг:
Код коллекции: 295046
Цена от 4 392 руб.
 Вся керамическая плитка и керамогранит производства Kerama Marazzi
Вся керамическая плитка и керамогранит производства Kerama Marazzi Также смотрите ITT Ceramic Mystic в нашем каталоге